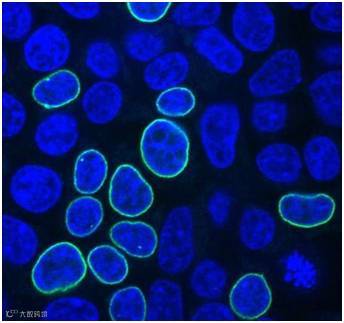

图片来自Alexandre Paix。
CRISPR/Cas9系统是目前发现存在于大多数细菌与所有古生菌中的一种免疫系统,被用来识别和摧毁入侵的噬菌体和其他的病原体。在这种系统中,CRISPR是规律间隔性成簇短回文重复序列(clustered regularly interspaced short palindromic repeats)的简称。在过去5年里,CRISPR/Cas9作为一种有效切割DNA的工具在科学界广受欢迎。它经改造后用于哺乳动物细胞中。本质上,这种工具是一套精简的分子“剪刀”。
科学家们普遍认为,细胞通过随机地插入一组核苷酸来修复CRISPR/Cas9系统诱导的DNA断裂。这通常会破坏任何位于发生断裂的DNA位点处的基因。
科学家们已知细胞有时利用供者DNA来修复细胞基因组中的断裂。然而,这种供者DNA序列本身不会自我插入到细胞基因组中的空白位点上。相反,这种供者DNA的每个末端都存在着一种同源臂(homology arm)以便封闭这种切割造成的空隙。
这些同源臂由与遗传密码匹配的DNA的完整部分重叠的核苷酸组成。这有助这种供者DNA“粘附到”完整的DNA上。
然而,鉴于供者DNA需要比较长的同源臂(特别是当插入较长的DNA序列、单链DNA或环状DNA时,而且也很难制备出较长的单链DNA和环状DNA),科学家们认为利用供者DNA修复DNA断裂是一种低效的方法。随着科学家们在CRISPR方面积累了更多的经验,关于供者DNA的最佳设计规则和供者DNA的同源臂长度的问题就出现了。
为了解答这些问题,在一项新的研究中,来自美国约翰霍普金斯大学的研究人员将不同的供者DNA组合插入到人胚胎肾细胞中,这些细胞以其生长良好的能力和经常用于癌症研究中而为人所知。他们使用携带着编码一种绿色荧光蛋白的基因的供者DNA,当这种基因成功地插入到细胞基因组中时,这种绿色荧光蛋白就会在细胞的核膜上发出绿色荧光。相关研究结果于2017年11月27日在线发表在PNAS期刊上,论文标题为“Precision genome editing using synthesis-dependent repair of Cas9-induced DNA breaks”。
约翰霍普金斯大学助理研究员Alexandre Paix发现线性DNA片段非常适合作为供者DNA,而且它们在人细胞中编辑DNA的效率比环状DNA(这里指质粒)高2~5倍。Paix说,“线性DNA在实验室中很容易通过PCR扩增法加以制备。”
Paix也测试了不同长度的同源臂。他发现最佳的同源臂长度大约为35个核苷酸(35nt),比科学家们通常使用的要短得多。
具体而言,这些研究人员发现长度为33~38nt的同源臂与长度为518nt的同源臂具有相同的编辑成功率,在最佳条件下产生10%~20%的编辑成功率。相反之下,当他们利用长度为15~16nt的同源臂进行测试时,这种基因插入成功率下降了一半。他们在人基因组的三个不同的位点上重复了这些结果。他们还发现新插入的DNA序列能够长达1000nt(不包括同源臂)。
这些研究人员利用长度为57~993nt的供者DNA序列取得的编辑成功率在10%~50%。更短的供者DNA要比更长的供者DNA取得更高的编辑成功率。比如,长57nt的供者DNA、长714nt的供者DNA和长993nt的供者DNA插入到细胞基因组靶位点上的成功率分别为45.5%、23.5%和17.9%。当长度超过1000nt时,长1122nt的供者DNA和长2229nt的供者DNA具有非常低的插入成功率---大约为0.5%。
约翰霍普金斯大学医学院基础研究副主任Geraldine Seydoux博士说,“在序列长度比较大时,导入编辑所需的供者DNA数量是非常困难的。细胞往往会因具有这么多的DNA而窒息。”
最后,这些研究人员还发现当供者DNA距离CRISPR/Cas9切割位点不到30nt时,编辑成功率达到最高。Seydoux说,“当这种距离超过30nt时,这种插入是不可行的。”
Seydoux补充道,“这些参数应当能够适用于科学家们试图编辑的大多数基因。事实上,大多数实验涉及对距离CRISPR切割位点仅两到三个核苷酸的位置进行编辑。”
这些研究人员也测试了这种方法是否能够在小鼠胚胎中发挥作用。通过使用具有长36nt的同源臂的PCR扩增片段,他们在87种小鼠胚胎中,成功地将一种长739nt的DNA序列(编码一种绿色荧光蛋白)插入到27种小鼠胚胎中。
这些研究人员已正在利用这些修复规则来研究秀丽隐杆线虫中的DNA,而且他们正在研究这些修复规则是否也适用于其他类型的人细胞。
Seydoux说,在这些修复规则被广泛采用之前,它们应当在更多的人细胞类型和其他的有机体中接受测试。(生物谷 Bioon.com)
参考资料:
Alexandre Paix, Andrew Folkmann, Daniel H. Goldman et al. Precision genome editing using synthesis-dependent repair of Cas9-induced DNA breaks. PNAS, Published online: 27 Nov 2017, doi:10.1073/pnas.1711979114
(来源:生物谷)



